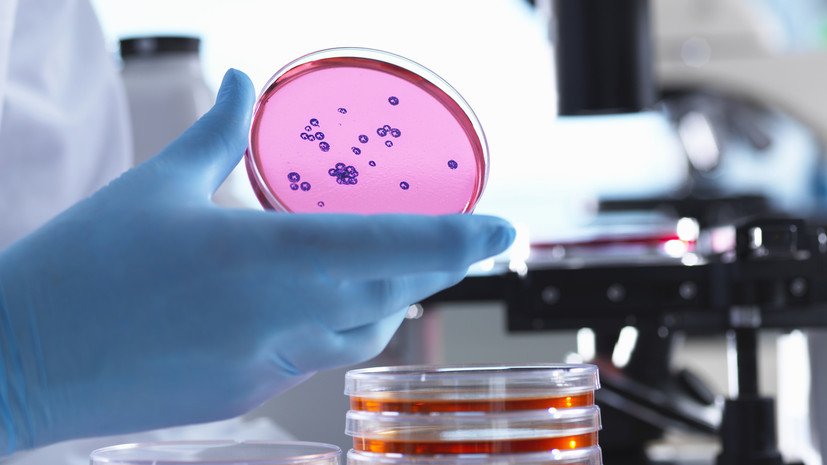

Бактерії — це мікроскопічні організми, які існують навколо нас і всередині нас. Вони настільки малі, що побачити їх можна лише під мікроскопом. Проте їх роль у житті людини надзвичайно велика.
Що таке бактерії
Бактерії — це одноклітинні живі істоти, які не мають ядра. Вони належать до прокаріотів. І хоча ці організми прості за будовою, їхні функції складні та різноманітні.
Де живуть бактерії
Насправді, бактерії можуть жити майже скрізь. Вони живуть у ґрунті, воді, повітрі, навіть у кратерах вулканів. Крім того, вони мешкають в організмах тварин, людей, рослин. Наприклад, у нашому кишківнику живе близько 100 трильйонів бактерій.
Які бувають види бактерій
Умовно бактерії поділяються на три основні групи: корисні, нейтральні та шкідливі. Корисні бактерії допомагають перетравлювати їжу або захищають від хвороб. Шкідливі ж можуть викликати інфекції або псувати продукти.
Як бактерії допомагають людям
Варто зауважити, що бактерії дуже корисні для нашого здоров’я. Вони беруть участь у травленні, зміцнюють імунітет та знищують шкідливі мікроорганізми. Наприклад, бактерії у йогуртах сприяють кращій роботі шлунка.
Бактерії в медицині
Бактерії відіграють важливу роль і в медицині. За допомогою них створюють пробіотики та ліки. Також вони допомагають вивчати механізми хвороб, тестувати нові препарати і навіть виробляти інсулін.
Бактерії в харчовій промисловості
У виробництві сиру, кефіру, йогуртів, солінь, квашеної капусти та ковбас бактерії відіграють головну роль. Вони допомагають продуктам ферментуватися і надають їм характерного смаку та аромату.
Як бактерії шкодять здоров’ю
Однак не всі бактерії є добрими. Деякі викликають хвороби, такі як ангіну, пневмонію, туберкульоз, сальмонельоз. Вони можуть передаватися через брудні руки, їжу або повітря. Саме тому важливо дотримуватися гігієни.
Як боротися з шкідливими бактеріями
Найкращий спосіб уникнути зараження — мити руки, правильно зберігати продукти та не вживати забруднену воду. У разі інфекцій лікарі призначають антибіотики. Але зловживати ними не варто, бо бактерії можуть до них звикнути.
Що таке антибіотики
Антибіотики — це ліки, які знищують або зупиняють ріст бактерій. Проте вони не діють на віруси. Саме тому при застуді або грипі антибіотики не допоможуть. Їх слід приймати лише за рекомендацією лікаря.
Опірність бактерій до ліків
Через надмірне використання антибіотиків бактерії навчилися пристосовуватися. Цей процес називається антибіотикорезистентністю. Якщо ми не будемо обережними, в майбутньому деякі інфекції буде неможливо вилікувати.
Бактерії у науці
Науковці щодня вивчають бактерії. Вони відкривають нові штами, створюють вакцини, розробляють методи боротьби з епідеміями. Дослідження мікробіому людини відкриває нові горизонти в медицині.
Мікробіом людини
Наше тіло — це дім для мільярдів бактерій. Всі вони разом утворюють мікробіом. Він впливає на настрій, вагу, імунну систему. Доглядаючи за ним, ми дбаємо про своє здоров’я.
Як підтримувати здоровий мікробіом
Щоб мати здоровий мікробіом, слід їсти багато клітковини, кисломолочних продуктів, овочів і фруктів. Варто уникати надмірного вживання цукру, жирної їжі, алкоголю і, звісно, не зловживати антибіотиками.
Бактерії в екології
Бактерії допомагають розкладати органічні речовини, очищають воду та ґрунт, переробляють відходи. Вони є основою багатьох екосистем і відіграють головну роль у кругообігу речовин.
Бактерії у космосі

Неймовірно, але бактерії побували навіть у космосі. Дослідження показали, що деякі з них здатні виживати у вакуумі та радіації. Вчені припускають, що бактерії могли бути першими формами життя у Всесвіті.
Генетична інженерія і бактерії
Сьогодні наука використовує бактерії для створення нових речовин — наприклад, біопалива або вітамінів. Завдяки генетичній інженерії можливо змінювати їх ДНК і програмувати на корисні функції.
Чому бактерії важливі для майбутнього
Без сумніву, бактерії — ключ до майбутніх інновацій. Вони допоможуть у створенні нових ліків, очищенні планети та розвитку екологічного сільського господарства. Бактерії — це союзники, а не вороги.
Цікаві факти про бактерії
- В одній чайній ложці ґрунту живе більше бактерій, ніж людей на Землі.
- Деякі бактерії можуть «світитися» у темряві.
- На кожну клітину тіла припадає близько 1,3 бактерії.
Як вивчають бактерії в школі
У шкільній біології діти вивчають основи мікробіології, знайомляться з видами бактерій, їхньою будовою та роллю. Це допомагає зрозуміти важливість чистоти, гігієни та здорового способу життя.
Як зацікавити дітей темою бактерій
Щоб дітям було цікаво, можна використовувати мікроскоп, проводити прості досліди, переглядати наукові мультфільми. Наприклад, створити «бактеріальний експеримент» з хлібом і подивитися, де він пліснявіє швидше.
Читати далі: Однорідні члени речення – просте пояснення для школярів з прикладами
Часті запитання про бактерії
Бактерії — це маленькі істоти, які живуть скрізь: у нас, на нас і навколо нас. Вони можуть бути корисними або шкідливими.
Вони допомагають травленню, підтримують імунітет і беруть участь у створенні продуктів, як-от йогурт або сир.
Ні, лише деякі викликають хвороби. Багато з них корисні й навіть необхідні для нашого організму.
Через часте вживання бактерії звикають до них, і ліки стають неефективними.
Мікробіом — це всі бактерії, що живуть у нашому тілі. Вони впливають на здоров’я, настрій і навіть на вагу.
Висновок
Бактерії — це справжнє диво природи. Хоча їх не видно, вони постійно впливають на наше життя. Від здоров’я до довкілля — ці крихітні істоти відіграють величезну роль. Варто знати про них більше, щоб краще піклуватися про себе та планету.